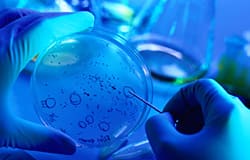

| March 5, 2010 | DHA destroys neuroblastoma cells | | An article in the March, 2010 issue of the Journal of the Federation of American Societies for Experimental Biology (FASEB Journal) reports the discovery by scientists at the Karolinska Institutet in Stockholm, Sweden, in collaboration with researchers at Brigham and Women’s Hospital and Harvard Medical School, of the ability of docosahexaenoic acid, or DHA, to kill neuroblastoma cells in vitro. Neuroblastoma is a cancer that originates in the sympathetic nervous system of an embryo or fetus. Five year survival is high when the disease is diagnosed in infancy, but averages 35 percent in children who develop the disease at a later age. It is currently treated with surgery, chemotherapy, radiation or bone marrow transplant. Docosahexaenoic acid is the most abundant fatty acid in the brain, and is necessary for proper neural development of the fetus. Increased DHA intake is associated with a number of benefits, including protection against several types of cancer. Helena Gleissman, PhD of Karolinska Institutet's Childhood Cancer Research Unit and her colleagues tested the effect of DHA on cultured neuroblastoma cells and analyzed them for DHA's metabolic byproducts. They found that while DHA itself destroyed the cancer cells, the fatty acid's derivatives were even more effective at killing these cells. The current study and previous research show that while DHA has been demonstrated to help protect neural cells from stress-induced apoptosis (programmed cell death), it also induces apoptosis in neuroblastoma cells. The discovery may be of significance for the treatment of other cancers, including those of the colon and prostate. "We hope that this study can provide a deeper understanding of the actions of omega-3 fatty acids and their products in cancer cells, and why they can be of such high importance in treatment of the disease," Dr Gleissman commented. "Ultimately, we hope that we can be able to cure more children with neuroblastoma, and possibly other cancers." "This is good news for those looking to stop cancer," FASEB Journal Editor-in-Chief Gerald Weissmann, MD remarked. "We now know that DHA plays both offense and defense when it comes to protecting our health. Its ability to help prevent numerous diseases is well documented, but now we see that DHA or one of its byproducts might serve as the starting point for a new class of anticancer drugs." | |  |  | | The use of Complementary and Alternative Medicine (CAM) is popular among cancer patients undergoing conventional treatment (Hann D et al 2005; Molassiotis A et al 2005). Over 72 million patients used complementary alternative therapies in the past year (Tindle HA et al 2005) to help control their disease. In the United States, 91 percent of cancer patients implemented at least one form of CAM in addition to undergoing conventional cancer treatment (Yates JS et al 2005). The most popular forms of CAM were exercise, relaxation, and prayer (Yates JS et al 2005). For centuries the Chinese have used garlic-containing herbal formulas to treat tumors, but scientists were challenged to find the mechanism that rendered it efficacious. Among those dedicated to validating garlic is Benjamin Lau, M.D., Ph.D. Dr. Lau, focusing upon cancer biology and immunology, was motivated by an epidemiological study reported by the People's Republic of China. The study compared two large populations in the Shandong Province: Cangshan County and Qixia County (Mei et al. 1982). Residents of Cangshan County experienced the lowest death rate due to stomach cancer (three per 100,000), regularly consuming about 20 grams of garlic a day; the people of Qixia had a 13-fold higher stomach cancer death rate, eating garlic only rarely. It appears that lowering nitrite concentrations may be the protective mechanism resulting in fewer numbers of gastric cancers. Garlic's anticarcinogenic effects are not restricted to gastric malignances. - Garlic (administered intralesionally to mice) was significantly more effective than BCG (bacillus Calmette-Guerin), a weakened form of the tuberculosis bacilli, in treating bladder cancer (Lau et al. 1986).
- Diallyl disulfide, a sulfur compound, induced cell death (apoptosis) in non small cell lung cancer cells (Hong et al. 2000); Diallyl sulfide, a component of garlic oil, inhibited liver carcinogenicity following carcinogenic exposure (Hayes et al. 1987); S-allyl cysteine, (a derivative of aged garlic extract), inhibited human neuroblastoma cell growth in vitro (Welch et al. 1992); allixin, one of the compounds of aged garlic extract, inhibited the development of skin cancer (Nishino et al. 1990). Diallyl sulfide was highly inhibitory during the initiation phase of esophageal cancer (Wargovich et al. 1992).
| Life Extension Magazine® March, 2010 issue now online 
- On the cover:
- Reports:
- Departments:
| |  | D-Ribose Powder   | | The primary source of energy for all cellular processes is a molecule known as ATP (adenosine triphosphate). Healthy, active cells constantly replenish their supply of ATP to produce vital cellular energy. However, under conditions of stress, injury, or aging, critical body tissues such as heart and skeletal muscles cannot produce ATP quickly enough to perform optimally. D-ribose, a carbohydrate molecule found in every living organism, facilitates the production of ATP. In studies of healthy athletes as well as those who have suffered injury to the heart muscle, supplying fatigued muscle cells with D-ribose quickly restored ATP levels to normal. By helping to rapidly refill depleted energy stores, D-ribose may be especially beneficial for people coping with cardiac and other problems marked by impaired cellular energy production. | | |   | | ArthroMax™ is the multinutrient formula designed to provide broad-spectrum support for aging joints and cartilage. And based on recent scientific findings, ArthroMax™ has been enhanced with higher potencies of certain ingredients and now also contains theaflavins. This ArthroMax™ formula contains more glucosamine sulfate along with a special Boswellia extract known as 5-LOXIN®. Glucosamine sulfate provides underlying structural foundation for joints while 5-LOXIN® inhibits the 5-lipoxygenase enzyme, thereby reducing levels of pro-inflammatory leukotriene B4. New studies have shown that a special fraction found in black tea suppresses pro-inflammatory cytokines at the genomic level. Scientists have found that these compounds called theaflavins uniquely down-regulate the expression of genes and cytokines associated with inflammatory conditions. | | | |  | | Life Extension Update | | What's Hot | | Life Extension Magazine® | |